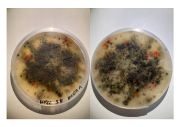

This special page shows all uploaded files.
| Date | Name | Thumbnail | Size | Description | Versions |
|---|---|---|---|---|---|
| 10:38, 20 January 2025 | Primary-succession-of-a-pond.jpg (file) |  |
15 KB | 1 | |
| 10:37, 20 January 2025 | Wetland pic.jpg (file) |  |
72 KB | 1 | |
| 13:37, 16 December 2024 | Spreading Ashes Performance 2 - Foto- Peechana Chayochaichana.jpg (file) |  |
8.51 MB | 1 | |
| 13:37, 16 December 2024 | Spreading Ashes Performance - Foto- Peechana Chayochaichana.jpg (file) |  |
6.71 MB | 1 | |
| 13:27, 16 December 2024 | Performance score- ghosts finding ghosts.jpg (file) |  |
10.54 MB | 1 | |
| 12:11, 16 December 2024 | I am ghosts that haunt themselves-2.pdf (file) | 49 KB | 1 | ||
| 11:48, 16 December 2024 | NEW-DOCUMENT- Typical Organisation for standards and order .jpg (file) |  |
81 KB | 1 | |
| 11:46, 16 December 2024 | Moodpboard image 1 -- ghosts finding ghosts.jpg (file) |  |
24 KB | 1 | |
| 11:45, 16 December 2024 | Fantasma - Jannete Mark.jpg (file) |  |
32 KB | 1 | |
| 11:38, 16 December 2024 | 241216ghosts finding ghosts tests 13.jpg (file) |  |
65 KB | 1 | |
| 11:37, 16 December 2024 | 241216ghosts finding ghosts tests 12.jpg (file) |  |
900 KB | 1 | |
| 11:37, 16 December 2024 | 241216ghosts finding ghosts tests 5.jpg (file) |  |
470 KB | 1 | |
| 11:36, 16 December 2024 | 241216ghosts finding ghosts tests 4.jpg (file) |  |
501 KB | 1 | |
| 11:36, 16 December 2024 | 241216ghosts finding ghosts tests 1.jpg (file) |  |
1.34 MB | 1 | |
| 11:35, 16 December 2024 | 241216finding ghosts tests.pdf (file) | 2.06 MB | 1 | ||
| 11:31, 16 December 2024 | I am ghosts that haunt themselves.pdf (file) | 132 KB | 1 | ||
| 11:20, 16 December 2024 | 141216wiki header ghosts.jpg (file) |  |
9.18 MB | 1 | |
| 11:57, 19 November 2024 | Asche IMG 5423.png (file) |  |
12.57 MB | 1 | |
| 11:52, 19 November 2024 | Asche IMG 5421.png (file) |  |
11.3 MB | 1 | |
| 11:49, 19 November 2024 | Asche IMG 5416.png (file) |  |
12.86 MB | 1 | |
| 11:46, 19 November 2024 | Asche under flow hood IMG 5421.jpg (file) |  |
2.34 MB | 1 | |
| 11:45, 19 November 2024 | AschebildIMG 5416.jpg (file) |  |
3.28 MB | 1 | |
| 11:42, 19 November 2024 | Ache pipette.jpg (file) |  |
3.28 MB | 1 | |
| 14:13, 18 November 2024 | Experimente 3 5.jpg (file) |  |
4.87 MB | 1 | |
| 14:13, 18 November 2024 | Experimente 3 4.jpg (file) |  |
4.57 MB | 1 | |
| 14:12, 18 November 2024 | Experimente 3 3.jpg (file) |  |
5.06 MB | 1 | |
| 14:12, 18 November 2024 | Experimente 3 2.jpg (file) | |
5 MB | 1 | |
| 14:12, 18 November 2024 | Experimente 3 1.jpg (file) |  |
4.83 MB | 1 | |
| 13:56, 18 November 2024 | Experimente 2 9.jpg (file) |  |
5.34 MB | 1 | |
| 13:55, 18 November 2024 | Experimente 2 8.jpg (file) |  |
5 MB | 1 | |
| 13:55, 18 November 2024 | Experimente 2 7.jpg (file) |  |
5.2 MB | 1 | |
| 13:55, 18 November 2024 | Experimente 2 6.jpg (file) |  |
5.52 MB | 1 | |
| 13:55, 18 November 2024 | Experimente 2 5.jpg (file) |  |
5.17 MB | 1 | |
| 13:54, 18 November 2024 | Experimente 2 4.jpg (file) |  |
5.25 MB | 1 | |
| 13:54, 18 November 2024 | Experimente 2 3.jpg (file) |  |
4.76 MB | 1 | |
| 13:54, 18 November 2024 | Experimente 2 2.jpg (file) |  |
5.03 MB | 1 | |
| 13:54, 18 November 2024 | Experimente 2 1.jpg (file) |  |
4.81 MB | 1 | |
| 00:14, 18 November 2024 | Asche exp 1 2.jpg (file) |  |
9.33 MB | 1 | |
| 00:14, 18 November 2024 | Asche exp 1 3.jpg (file) |  |
4.3 MB | 1 | |
| 00:13, 18 November 2024 | Asche exp 1 1.jpg (file) |  |
4.55 MB | 1 | |
| 23:58, 17 November 2024 | Ache IMG 5464.jpg (file) |  |
2.53 MB | 1 | |
| 23:57, 17 November 2024 | Ache IMG 5462.jpg (file) |  |
2.64 MB | 1 | |
| 23:55, 17 November 2024 | Asche IMG 5446.jpg (file) |  |
2.86 MB | 1 | |
| 20:43, 17 November 2024 | Ash IMG 5460.jpg (file) |  |
2.74 MB | 1 | |
| 20:41, 17 November 2024 | Ash-IMG 5457.jpg (file) |  |
2.52 MB | 1 | |
| 20:15, 17 November 2024 | Second succesion ghost story header.jpg (file) |  |
7.51 MB | 1 | |
| 14:31, 4 November 2024 | Haunted by Systems, Haunted by Loss.pdf (file) | 95 KB | 1 | ||
| 13:21, 4 November 2024 | Screenshot 2024-11-04 at 14.01.43.png (file) |  |
11.62 MB | 1 | |
| 13:19, 4 November 2024 | Screenshot 2024-11-04 at 14.01.54.png (file) |  |
13.59 MB | 1 | |
| 13:14, 4 November 2024 | Screenshot 2024-11-04 at 14.02.04.png (file) |  |
10.87 MB | 1 |